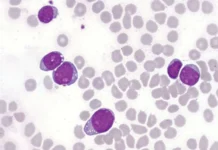
Nova terapia se mostra promissora contra câncer raro
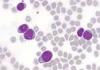
Nova terapia se mostra promissora contra câncer raro

Até pouco tempo, um terreno no Conjunto A da QNM 21/23, em Ceilândia, era utilizado para descarte irregular de lixo. No entanto, graças a um esforço conjunto entre órgãos do Governo do Distrito Federal (GDF) e a comunidade, o local foi revitalizado e passou a abrigar um projeto social que oferece aulas gratuitas de beach tennis para pessoas em situação de vulnerabilidade.
Antes de se tornar uma arena esportiva, o espaço passou por uma série de melhorias, incluindo limpeza geral, pintura de meio-fios e instalação de equipamentos, com o trabalho da Administração Regional de Ceilândia e da Companhia Urbanizadora da Nova Capital do Brasil (Novacap).
Agora, por meio de uma iniciativa do Instituto Reciclando o Futuro, em parceria com o Instituto Calango Urbano, a população local tem acesso a aulas gratuitas de beach tennis.
Embora a modalidade seja frequentemente associada a um público de elite, devido aos custos elevados com mensalidades, equipamentos e aluguel de quadras, o projeto torna o esporte acessível a todos que desejam participar.
“Trata-se de uma soma de esforços com o objetivo de oferecer, por meio do esporte, mais qualidade de vida e um novo olhar sobre a realidade para aqueles que, de outra forma, não teriam condições financeiras de praticá-lo”, destaca Renata D’Aguiar, fundadora do Instituto Reciclando o Futuro.
As aulas ocorrem todas as sextas-feiras em três horários: das 7h às 7h50, das 8h às 8h50 e das 9h às 9h50. Todo o material esportivo necessário, incluindo raquetes e bolas, é fornecido aos participantes.
Os interessados em se inscrever ou obter mais informações podem acessar o perfil oficial do instituto no Instagram.
*Com informações da Novacap
Por Agência Brasília
Foto: Divulgação/Novacap / Reprodução Agência Brasília